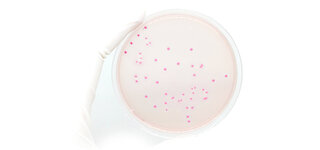

VIELE FUNKTIONEN – EINFACHE BEDIENUNG
Die integrierte Steuer- und Bedieneinheit mit übersichtlich gestaltetem Display ermöglicht eine komfortable und einfache Bedienung der WaterLine ROC-Anlage.
- Anzeige von Stör- und Betriebsmeldungen
- Wartungsanzeige und Betriebsstundenzähler
- Leitfähigkeitsanzeige (Permeat) mit einstellbarem Grenzwert der maximal zulässigen Wasserleitfähigkeit
(Sicherheitsabschaltung der Anlage bei Überschreitung aktivierbar)
- Externe Freigabe über potentialfreien Kontakt möglich
- Programmierbare Zwangsspülung
- Integrierter Druckschalter
Optionale Funktionen und Komponenten:
- Justierbare Verschneideeinheit zur Erhöhung der Permeatleitfähigkeit (bei der Verwendung mit Elektrodendampfluftbefeuchter und optionalem Leitfähigkeitssensor)
- Externer UV-Desinfektor für maximale Hygienebedingungen
- Druckausdehnungsgefäß für gleichbleibenden Druck zwischen 2-4 bar, Volumen wahlweise 18 oder 40 Liter
(mit Wandhalterung – Stand-Druckausdehnungsgefäß auf Anfrage möglich)
PLATZSPARENDE WANDMONTAGE UND SCHNELLE INSTALLATION
Die WaterLine ROC kann auf engstem Raum auf eine tragfähige Wand montiert werden. Damit die Installation möglichst schnell und einfach verläuft, wird die gesamte Anlage auf einer korrosionsbeständigen Montageplatte anschlussfertig geliefert. Sie wird über vier Montagepunkte (Ø 10 mm) an einer tragfähigen Unterkonstruktion befestigt.